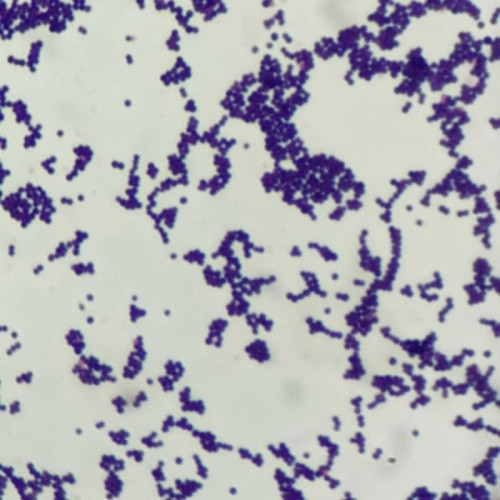

👏双十一品牌冰点福利❗️买一锅送一锅🔥‼️到手=烤肉煎盘+炖煮锅🍳 百年德国锅具品牌🇩🇪🌈【德世朗DESLON抗菌不粘锅】🌿两件套锅 ⚠️抗菌程度为I级❣️
| 运费: | 免运费 |
| 库存: | 200 件 |
商品详情


先上波实拍!! 看着就疯狂心动💗 没想到用起来也这么惊艳! 一锅顶两锅 上得厨房下得厅堂👍🏻👍🏻👍🏻





样品还烫手的厨房好锅来了!! (PS:验货的每一个团长都自留了) 有这锅,家里的菜式都丰富了起来……


从未见过如此新颖的锅!! ❗一锅两用 20cm炖锅+18cm煎锅 盖子翻过来就是一个小煎盘🍳 ♨️锅体可炖、煮、焖、熬…… ♨️煎盘可煎鸡蛋、牛排、甚至烤肉…… 十八项全能的多边形战士锅




🍳拿到手的第一感觉就是质感很好 🔺德系的精工品质值得放心 一体成型 锅体流畅✅ 整个锅的气质特别高级 高颜值奶油白,朱砂红两色可选



🔰抗菌材料和工艺原因 原本这口锅的造价就高 大家随便搜,带抗菌二字的都贵‼️ 官方在某橙色软件标价298一口🍳 ⚠开团只要69元!! ⚠️电磁炉电陶炉不可用哦

来自德国🇩🇪的百年品牌 ⚠买锅一定要买大牌! 德世朗DESLON创于1875年 米其林大厨挚爱 把源自德国的厨具理念传播到世界各地的厨房 以其一流的品质和独特的设计享誉全球


✅煎、炒、炸、煮一锅完美搞定,适用于家里2-5口人 ✅精铁一体成型,德系精工品质 ✅美国杜邦Teflon不沾涂层,轻油烟,易清洗 ✅健康安心,抗菌效率达到了99%(含检测报告) ✅德系精工细节,一流品质,实用与美观兼具


🔺始于颜值,忠于品质 ⭐️高抗菌 优选抗菌不粘材料,抗菌率高达99.9% ⭐️不粘锅 高科技不粘涂层,轻油少烟易清洁 ⭐️导热快 精铁材质制造,传热更快且受热均匀 到手两件:煎锅+炖锅!!


锅到手的第一时间 就测试它是否有传说中这么不粘 🔺实验证明:德系厨具诚不欺我 为了较真,特别挑战只用滴油煎蛋 结果完全成功!!😚 不粘的同时也好清洗 复合底很好的让食材受热均匀 因此 油烟很少♨️省时省力 确实是实用与便利的完美结合!



这个锅还有一个特别值得夸的点: 🔺🔺抗菌率高达99%❗ 家庭环境中对人体健康危害最大的细菌主要为大肠杆菌和金黄色葡萄球菌 首当其冲就是厨具用品,一不小心就“菌”从口入! ❌尤其有”人类健康头号杀手”之称的大肠杆菌 它会侵入婴儿和年老体弱者的血液 引起严重腹泻和败血症 ❌金黄色葡萄球菌是一种常见的食源性致病菌 引起的感染占第二位,仅次于大肠杆菌 在空气、水、灰尘中都有其踪影 这两种细菌,是你无论一天擦洗多少次也无法抑制其快速繁殖的! 得要有抗菌的锅,才能煮出让家人健康的美食呀❗

✅真正抑菌的锅! 实验室报告证明:德世朗两用锅涂层 对大肠杆菌和金黄色葡萄球菌的抗菌率达99.99% ✅抗菌程度为I级 从源头减少甚至杜绝细菌滋生的可能性 吃到肚子里的每一口美食都安心~



🔰符合国家卫生标准的不粘工艺 不含重金属有害物质 安全健康 新手也能轻松驾驭煎炸食物 丝滑到飞起💯
















- 懂货好单线报
- 你懂我,我懂货,爆品一起来团购
- 扫描二维码,访问我们的微信店铺